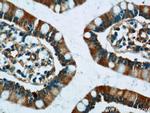
FICD Antibody in Immunohistochemistry (Paraffin) (IHC (P))

Search
Proteintech
FICD Polyclonal Antibody
{{$productOrderCtrl.translations['antibody.pdp.commerceCard.promotion.promotions']}}
{{$productOrderCtrl.translations['antibody.pdp.commerceCard.promotion.viewpromo']}}
{{$productOrderCtrl.translations['antibody.pdp.commerceCard.promotion.promocode']}}: {{promo.promoCode}} {{promo.promoTitle}} {{promo.promoDescription}}. {{$productOrderCtrl.translations['antibody.pdp.commerceCard.promotion.learnmore']}}
产品信息
11974-1-AP
种属反应
宿主/亚型
分类
类型
抗原
偶联物
形式
浓度
规格
纯化类型
保存液
内含物
保存条件
运输条件
产品详细信息
Immunogen sequence: ADYLYTRAL TISPYHEKAL VNRDRTLPLV EEIDQRYFSI IDSKVKKVMS IPKGNSALRR VMEETYYHHI YHTVAIEGNT LTLSEIRHIL ETRYAVPGKS LEEQNEVIGM HAAMKYINTT LVSRIGSVTI SDVLEIHRRV LGYVDPVEAG RFRTTQVLVG HHIPPHPQDV EKQMQEFVQW LNSEEAMNLH PVEFAALAHY KLVYIHPFID GNGRTSRLLM NLILMQAGYP PITIRKEQRS DYYHVLEAAN EGDVRPFIRF IAKCTETTLD TLLFATTEYS VALPEAQPNH SGFKETLPVK P (159-458 aa encoded by BC001342)
靶标信息
Protein that can both mediate the addition of adenosine 5'-monophosphate (AMP) to specific residues of target proteins (AMPylation), and the removal of the same modification from target proteins (de-AMPylation), depending on the context. The side chain of Glu-231 determines which of the two opposing activities (AMPylase or de-AMPylase) will take place. Acts as a key regulator of the ERN1/IRE1-mediated unfolded protein response (UPR) by mediating AMPylation or de-AMPylation of HSPA5/BiP (PubMed:25601083). In unstressed cells, acts as an adenylyltransferase by mediating AMPylation of HSPA5/BiP at 'Thr-518', thereby inactivating it. In response to endoplasmic reticulum stress, acts as a phosphodiesterase by mediating removal of ATP (de-AMPylation) from HSPA5/BiP at 'Thr-518', leading to restore HSPA5/BiP activity. Although it is able to AMPylate RhoA, Rac and Cdc42 Rho GTPases in vitro, Rho GTPases do not constitute physiological substrates (PubMed:19362538, PubMed:25601083). [UniProt]
仅用于科研。不用于诊断过程。未经明确授权不得转售。
篇参考文献 (0)
生物信息学
蛋白别名: adenosine monophosphate-protein transferase FICD; AMPylase; AMPylator FICD; De-AMPylase FICD; FIC domain containing; FIC domain-containing protein; fic S-phase protein cell division homolog; HIP-13; Huntingtin interacting protein E; huntingtin interactor protein E; Huntingtin yeast partner E; Huntingtin-interacting protein 13; Huntingtin-interacting protein E; MGC5623; Protein adenylyltransferase FICD
基因别名: D5Ertd40e; FICD; HIP13; HYPE; SPG92; UNQ3041; UNQ3041/PRO9857
UniProt ID: (Human) Q9BVA6, (Mouse) Q8BIX9, (Rat) Q6AY47
Entrez Gene ID: (Human) 11153, (Mouse) 231630, (Rat) 288741